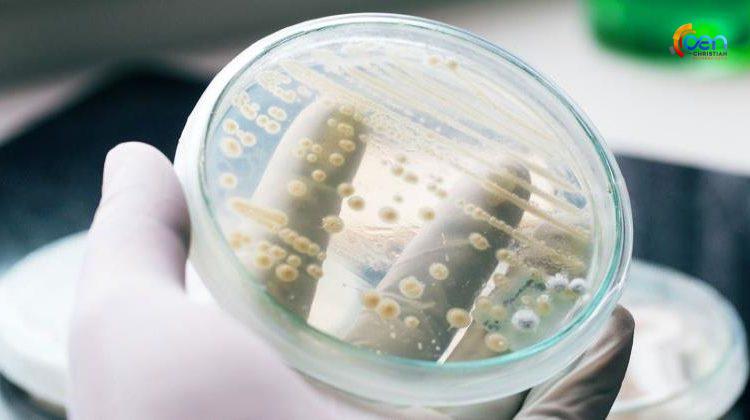

കോവിഡിന് പിന്നാലെ ഫംഗസ് ബാധ; അമേരിക്കയില് ആശങ്കയായി കാന്ഡിഡ ഓറിസ് വ്യാപനം: വാഷിങ്ടണില് നാലു കേസുകള്
വാഷിങ്ടണ്: അമേരിക്കയില് അപകടകാരിയായ കാന്ഡിഡ ഓറിസ് ഫംഗസ് നാലുപേരില് കണ്ടെത്തി. ഉയര്ന്ന മരണനിരക്കും മരുന്നിനെതിരെ ശക്തമായ പ്രതിരോധവും വേഗത്തില് വ്യാപിക്കുന്ന രീതി തുടങ്ങിയവ കാന്ഡിഡ ഓറിസിന്റെ പ്രത്യേകതകളാണ്.
ജനുവരി 10നാണ് വാഷിങ്ടണില് ആദ്യ കേസ് സ്ഥിരീകരിച്ചത്. പിന്നീട് കഴിഞ്ഞ ആഴ്ചയാണ് സിയാറ്റിലിനിലും കിങ് കൗണ്ടിയിലും മൂന്ന് കേസുകള് കണ്ടെത്തിയത്.
സാധാരണ ആന്റിഫംഗല് മരുന്നുകളെ പ്രതിരോധിക്കുന്ന കാന്ഡിഡ ഓറിസ് ഫീഡിംഗ് ട്യൂബുകള്, ശ്വസന ട്യൂബുകള്, കത്തീറ്ററുകള് തുടങ്ങിയവയുടെ ഉപയോഗത്തിലൂടെ ആശുപത്രികളിലാണ് വേഗത്തില് വ്യാപിക്കുന്നത്.
മനുഷ്യരില് നിന്നും മനുഷ്യരിലേക്ക് പകരുന്ന ഫംഗസ് ബാധയ്ക്ക് രോഗലക്ഷണങ്ങള് പലവിധത്തിലായിരിക്കും. കുറഞ്ഞ രോഗപ്രതിരോധ ശേഷിയുള്ളവരെയാണ് ഫംഗസ് ഏറ്റവും കൂടുതല് ബാധിക്കുക. ശരീരത്തിന്റെ വിവിധ ഭാഗങ്ങളെ ഫംഗസ് ബാധിച്ചേക്കാം. ചെവിയിലൂടെയോ, തുറന്ന മുറിവുകളിലോ, രക്തത്തിലാകെയോ അണുബാധ പിടിപെടാം. പലര്ക്കും പല രീതിയിലാകും രോഗലക്ഷണങ്ങളുടെ തീവ്രത.
കാന്ഡിഡ ഓറിസ് ബാധയുള്ള ഒരാള് സ്പര്ശിക്കുന്ന പ്രതലങ്ങളിലോ വസ്തുക്കളിലോ രോഗബാധയുണ്ടാകും. അതുവഴിയാണ് പലപ്പോഴും മറ്റ് രോഗികളിലേക്ക് അസുഖമെത്തുന്നത്. അണുബാധയുള്ളവര് നിര്ബന്ധമായും ഐസ്വലേഷനില് കഴിയണം.
പതിനഞ്ചു വര്ഷം മുമ്പ് ജപ്പാനിലാണ് കാന്ഡിഡ ഓറിസ് ആദ്യം റിപ്പോര്ട്ട് ചെയ്തത്. ഇംഗ്ലണ്ടില് 2016ലും ഇതേ ഫംഗസ് വ്യാപിച്ചിരുന്നു. ഈ ഫംഗസ് മരുന്ന് മൂലം പ്രതിരോധിക്കാന് സാധിക്കുന്നതല്ലെന്നാണ് ആരോഗ്യ വിദഗ്ധര് ചൂണ്ടിക്കാണിക്കുന്നത്.


